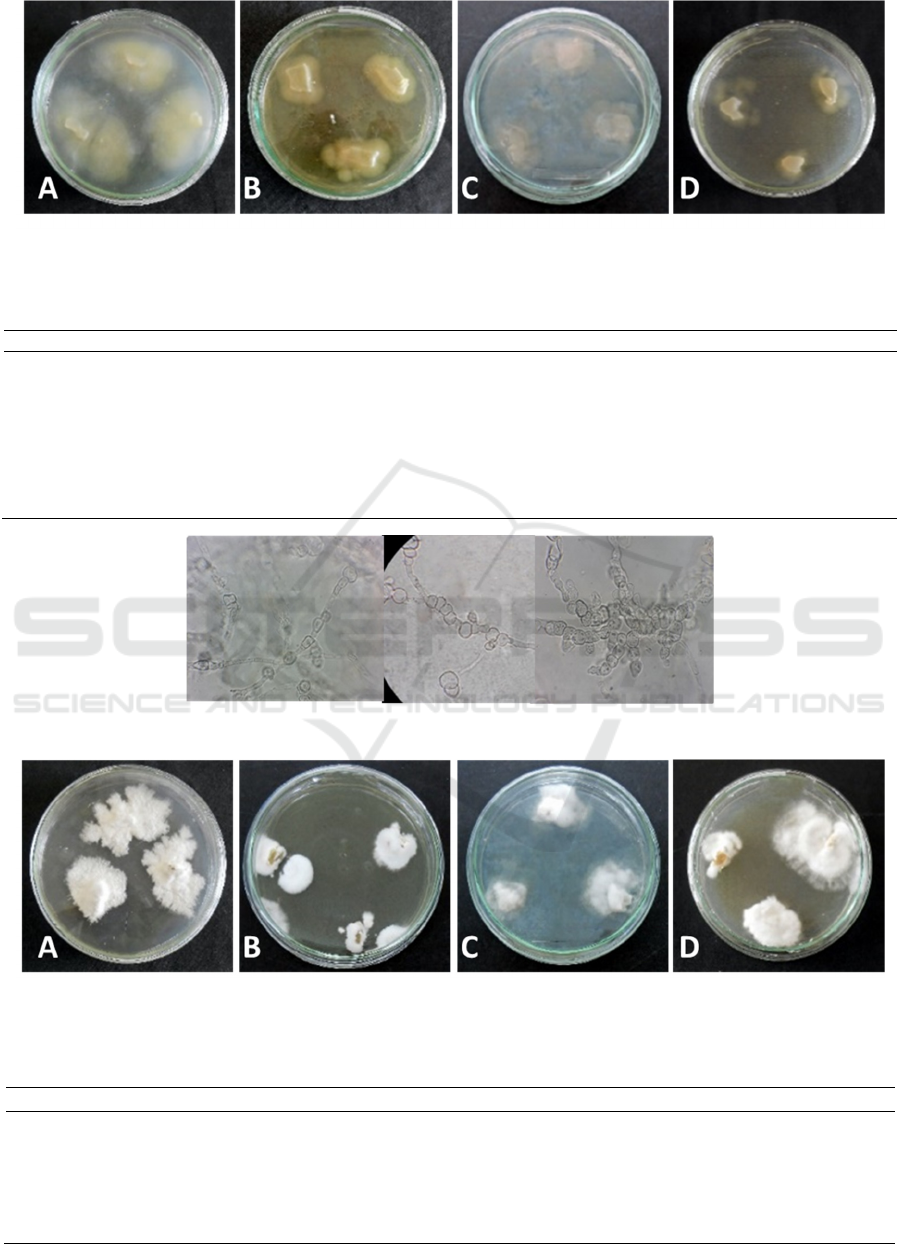
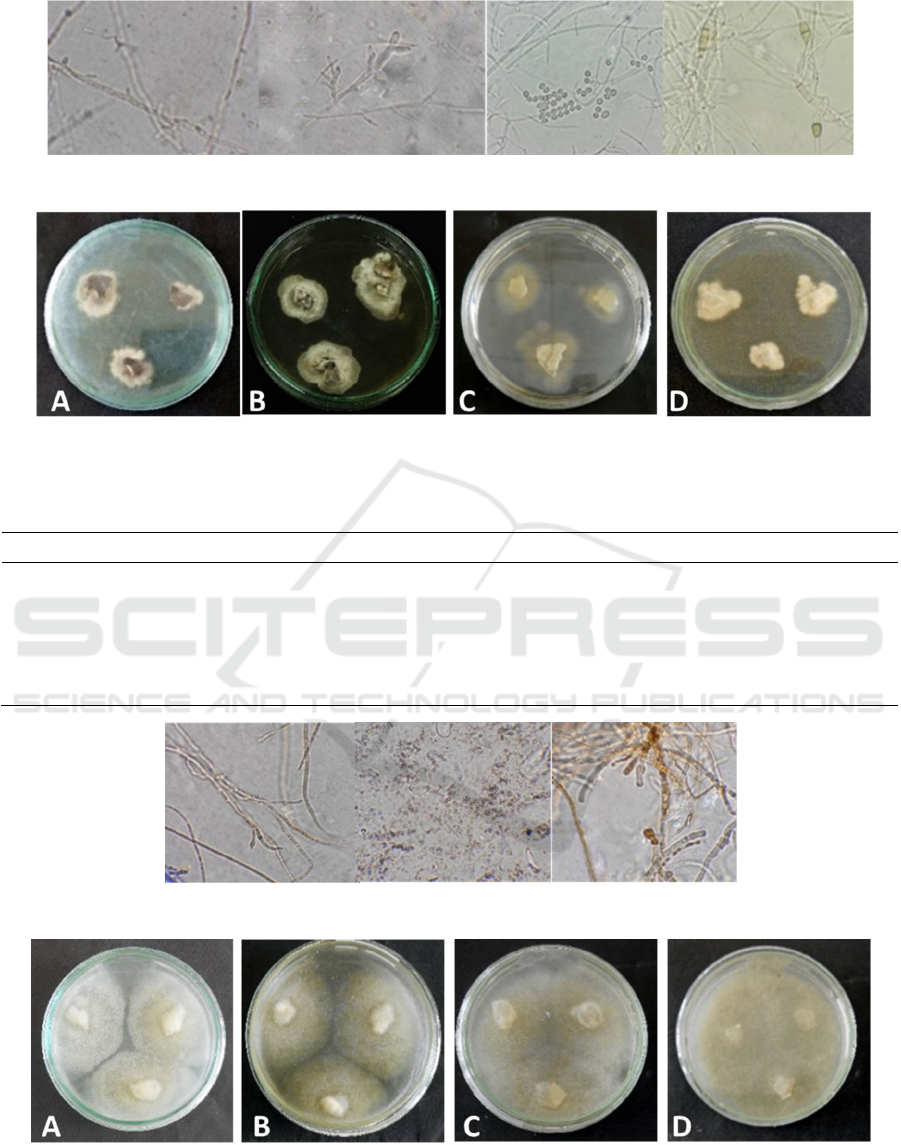

Screening of Endophytic Fungi of Melaleuca cajuputi Powell Leaves
as Antibacterial Sources
Hary Widjajanti, Salni, Niken Irfa Nastiti and Elisa Nurnawati
Department of Biology, Faculty of Mathematics and Natural Sciences, Sriwijaya University, Palembang, Indonesia
Keywords: Antibacterial, Endophytic fungi, Melaleuca cajuputi Powell.
Abstract: Melaleuca cajuputi leaves contain high flavonoids, flavonoids are chemical compounds that are
antibacterial. Antibacterial bioactive compounds are found in plants, but the use of plants as an antibacterial
source requires a large amount of biomass. Endophytic fungi that live in plant tissue can produce secondary
metabolites that potentially as an antibacterial compounds. Isolation of the endophytic fungi for antibacterial
sources can reduce the large amount of plant as a source of antibacterial agents. The aims of this research
were obtain endophytic fungi of M.cajuputi leaves as an antibacterial sources. The research stages were
sampling, isolation and purification of endophytic fungi, cultivation and production of secondary
metabolites, antibacterial activity and the minimum inhibitory concentration (MIC) tests, thin layer
chromatography, and characterization and identification of endophytic fungi that potentially as an
antibacterial sources. The results there were 7 isolates of endophytic fungi from Melaleuca cajuputi leaves.
MC
1
, MC
2
, MC
3
, and MC
4
fungal isolates have a strong antibacterial activities. The MIC of MC
2
and MC
3
extracts on Escherichia coli were 400 μg/mL and 100 μg/mL. The MIC of MC
1
and MC
4
extracts on
Staphylococcus aureus were 200 µg/mL and 700 µg/mL, respectively. The extract of four endophytic fungi
contain phenol and flavonoid that potentially as an antibacterial. Endophytic fungi MC
1
isolate identified as
Scopulariopsis candida, MC
2
isolate as Fusarium equiseti, MC
3
isolate as Fusarium sporotrichoides, and
MC
4
isolate as Mucor hiemalis.
1 INTRODUCTION
A number of plants have been passed down from
generation to generation used as medicine by almost
every community, including in Indonesia. Plants that
are used as medicinal plants, have now begun to be
explored scientifically by analyzing the content of
active compound that cause medicinal properties.
The active compound in the plant are too few or
minor, therefore if it is to be developed on a large
scale there are constraints from the raw material of
the plant that must be in large quantities.
Antibacterial compounds in the form of crude
extracts produced from plants when purified, the
amount will be even less. These obstacles make it
very difficult if the development of bioactive
compounds from medicinal plants that are rare and
endemic will be carried out. This is because if rare
plants are explored for bioactive compounds to be
taken, then the sustainability of these plants is
threatened. These constraints can be anticipated by
isolating microbes, especially endophytic fungi that
are symbiotic with these plants. The technique used
to take only a few parts of plants commonly used in
traditional medicine, then the isolation of endophytic
fungi from the plant parts is done, so that rare
medicinal plants will remain sustainable and the
development of medicinal compounds from these
plants through endophytic fungi can be developed.
The development of medicinal plants based on
medicinal plants must be considered aspects of
preservation of medicinal plants. One technology
that can be done was isolate endophytic fungi from
parts of medicinal plants that are often used as
traditional medicine and selection of bioactive of
secondary metabolites such as antibacterial from the
culture of endophytic fungi, thus the development of
medicinal plants based on medicinal plants can be
done and the preservation of medicinal plants
especially that are already scarce can be maintained.
Endophytic fungi are fungi that live in plant
tissues in a certain period and are able to live by
forming colonies in plant tissue without endangering
the host. Each higher level plant can contain several
196
Widjajanti, H., Salni, ., Irfa Nastiti, N. and Nurnawati, E.
Screening Endophytic Fungi of Melaleuca cajuputi Powell Leaves as Antibacterial Sources.
DOI: 10.5220/0010139000002775
In Proceedings of the 1st International MIPAnet Conference on Science and Mathematics (IMC-SciMath 2019), pages 196-204
ISBN: 978-989-758-556-2
Copyright
c
2022 by SCITEPRESS – Science and Technology Publications, Lda. All rights reserved

endophytic microbes that produce secondary
metabolites that are suspected as a result of
coevolution or genetic recombination from host
plants to endophytic microbes (Tan and Zou (2001),
Strobel and B.Daisy (2003).
The ability of endophytic fungi to produce
secondary metabolites in accordance with their host
plants is a very large and reliable opportunity to
produce secondary metabolites from endophytic
microbes isolated from these host plants.
Approximately 300,000 species of plants scattered
on this earth, each plant contains one or more
endophytic microbes consisting of bacteria and fungi
(Strobel and Daisy, 2003). If the endophytes
isolated from a medicinal plant can produce the
same alkaloids or secondary metabolites as the
original plants or even in higher amounts, then we
don't need to cut down the original plants to be taken
as simplicia, which is likely to take decades to be
harvested (Radji,2005). According to Stierlie et al.
(1995) the use of endophytic microbes in producing
active compounds has several advantages, including
(1) faster producing of uniform quality, (2) can be
produced on a large scale, and (3) the possibility of
obtaining new bioactive components by providing
conditions that are new different.
M. cajuputi can live on land that has limited
nutrients from fertile soil and is rich in nutrients.
This plant is also able to live in soil with critical
conditions with little nutrient elements. M.cajuputi
leaves in Indonesia are widely used as raw materials
in the production of eucalyptus oil (Widiana et al,
2014). M.cajuputi leaves has many benefits, one of
which can be used as an antibacterial source (Al-
Abd et al., 2015). Melaleuca cajuputi has potential
as an antibacterial, antioxidant, and even potentially
as an antifilaria. (Al-Abd
2
et al., 2016). M.cajuputi
has been used traditionally for the treatment of
diseases such as coughing, stomach cramps, burns,
and influenza. This plant also exhibits anti-
inflammatory, antidengue, anticancer and
anticonvulsant activities. The active compound of
M.cajuputi leaves were trans caryophyllena, β-
selinene, germacrena (C15H26O), neopitadiene,
cyclohexakarboksal dehide, β-caryophyllena, 3-
methoxy benzoic acid trimethylsilan; limonene; 1,4
naphthoquinone-5,8-dihydroxy-2-methoxy; 3
carena; α-caryophylena; cineol; patchulin; ethyl
benzene; benzene 1-metil-3 (metiletyl), and 1.3%
volatile oil [10]. Essential oils are one of the
compounds found in plants that have antibacterial
activity (Ajizah, 2014).
M. cajuputi leaves also contain high flavonoids,
flavonoids are chemical compounds that are
antibacterial (Al-Abd et al., 2015). The aims of the
research were 1). Get endophytic fungi isolates from
Melaleuca cajuputi Powell that are able to produce
secondary metabolites that are antibacterial and
antioxidant, 2). Conducting in vitro tests to verify
the antibacterial and antioxidant properties of
secondary metabolites of the plant's endophytic
fungi of Melaleuca cajuputi Powell, 3). Identify the
isolates of endophytic fungi of Melaleuca cajuputi
Powell which have high potential to produce
antibacterial.
2 MATERIALS AND METHOD
2.1 Isolation and Purification of
Endophytic Fungi
The sterile leaves are cut 2x1 cm aseptically, then
placed in a commercial Potato Dextrose Agar
powder (PDA)(20 g dextrose, 15 agar, and 4 g
potato starch) medium. Incubated at room
temperature until the fungi appeared to grow. The
different fungal colonies on PDA medium are
further purified on new PDA medium.
2.2 Cultivation of Endophytic Fungi
and Secondary Metabolite
Extraction
Twenty agar plug of endophytic fungi isolates
inoculated into 500 mL Potato Dextrose Broth
(PDB) medium and incubated at room temperature
for ± 30 days. After a change in the color of the
medium which indicates the production of secondary
metabolites, the medium was extracted using an
ethyl acetate solvent (1: 1) and concentrated with a
rotary evaporator to obtain a crude extract of
secondary metabolites (Jamal et al., 2008).
2.3 Antibacterial Test
A 0.5 McFarland standard is prepared by mixing
0.05 mL of 1.175% barium chloride dihydrate
(BaCl
2
.2H
2
O), with 9.95 mL of 1% sulfuric acid
(H
2
SO
4
). The 0.5 Mc Farland solution measured the
absorbance using a UV-Vis spetrophotometer (625
nm). The absorbance value obtained is equivalent to
1.5x10
8
bacterial cells/mL (Fatisa, 2013).
Escherichia coli, Staphylococcus aureus,
Salmonella typhimurium, and Shigella dysentriae
were inoculated into a physiological saline solution
(0.85% NaCl) then homogenized and measured their
Screening Endophytic Fungi of Melaleuca cajuputi Powell Leaves as Antibacterial Sources
197

absorbance using a UV-Vis spectrophotometer (625
nm). The absorbance of the suspension test bacteria
was prepared similar to the McFarland standard
solution to reach the density of 1.5×10
8
CFU/mL
(Kumala, 2014).
The antibacterial activity test was performed
using disc diffusion method (Kirby-Bauer). The
bacterial suspension was inoculated as much as 0.1
ml into a Mueller-Hinton Agar (MHA) medium with
a spread plate methods. Crude extracts of secondary
metabolites made concentrations of 400 μg/disc
(4%) and standard antibiotic tetracycline 30 μg/disc
(0.3%) as positive control. The disc paper saturated
in a solution of secondary metabolite extract and
tetracycline antibiotics then inoculated on the
surface agar containing bacterial suspension and
incubated atroom temperature for 24 hours (Islam et
al., 2013). The criteria for each concentration of
antibacterial compounds tested against standard
antibiotics were determined by weak : A/B x 100%
<50%; medium : 70% <A/B x 100%>50%; strong :
A/Bx100% >70%, with A was clear zone diameter
of extract and B was clear zone diameter standard
antibiotic (Chan, 2007).
2.4 Determination of Minimum
Inhibitory Concentration (MIC)
Secondary metabolite extracts that had strong
antibacterial activity determined the minimum
inhibitory concentrations. Determination of KHM
using disc diffusion methods. The concentrations to
be used were 4%, 3%, 2%, 1% and 0 (as a control).
Paper discs that have been saturated with extracts of
each of the existing concentrations and tetracycline
as a standard antibiotics are placed on the surface of
MHA medium that has been inoculated with the
suspension of the test bacteria. Incubated at room
temperature for 24 hours. Inhibition zones are
measured and a minimum concentration value that
can inhibit bacteria was determined.
2.5 Thin Layer Chromatography
Analysis
Endophytic fungal extracts which have high
antibacterial activity then analyzed by TLC. Thin
layer chromatography analysis using silica gel 60
plates with ethyl acetate and n-hexane solvents with
the eluent ratio used (ethyl acetate: n-hexane) were
1: 4; 3: 2; 2: 3 and 4: 1. The formed spots were seen
by using UV light with a wavelength of 366 nm, and
the Rf value of the compound formed was
determined (Jamal et al., 2008).
2.6 Characterization and Identification
of Endophytic Fungi
Fungal endophytes were growth on Potato Dextrose
Agar (PDA), Czapek Dox Agar (CDA), Czapek
Yeast Extract Agar (CYEA), and Malt Extract Agar
(MEA) media at room temperature (28
o
C) for 7
days. Fungal colonies grown in each medium
observed about colony color, colony diameter,
medium color around the colony, and colony reverse
color (Srikandace, 2007). Microscopic morphology
observed were hypha (septate or not), hyaline
(colorless) or dark pigmented hyphae (greenish or
blackish brown, dark black, grayish black), spores
(asexual and sexual) with Henrici's Slide Cuture
(HSC) methods (Gandjar et al., 1999).
3 RESULTS AND DISCUSSION
3.1 Antibacterial Activity of Secondary
Metabolite of Endophytic Fungi
Isolation and purification of endophytic fungi of
Melaleuca cajuputi Powell leaves obtained 7
isolates, 5 isolates from the young leaves and 2
isolates from the old leaves. The antibacterial
activity test of Melalleuca cajuputi endophytic fungi
extract on Escherichia coli showed that there were
two endophytic fungi isolates had the highest
antibacterial activity, i.e MC3 and MC5 fungi
isolates with 11 mm and 10 mm clear zone diameter.
Five isolates did not have antibacterial activity on E
coli namely MC1, MC2, MC4, MC6, and MC7
isolates. The antibacterial activity of a secondary
metabolite extract varies with bacteria depending on
the components of the bioactive compound in the
extract.
Extracts of secondary metabolites of endophytic
fungi that have the highest antibacterial activity on
Staphylococcus aureus were extract of MC1 and
MC7 fungal isolates, with 10 mm and 11 mm clear
zone diameter.
IMC-SciMath 2019 - The International MIPAnet Conference on Science and Mathematics (IMC-SciMath)
198

Table 1: Antibacterial activity of endophytic fungi of M cajuputi leaves against E coli, S aureus, S typhi, S. dysenteriae
using the disc-diffusion methods.
Isolates
Zone of inhibition in mm (inhibition %)
E coli S aureus S typhi S dysenteriae
MC1 0 10(90.9)
+++
0 8,13(42.5)
+
MC2 0 0 7(63.4)
++
12.04(62.9)
++
MC3 11(100)
+++
9(81.8)
+++
6,12(55.4)
++
9.14(47.8)
+
MC4 0 0 0 9,02(47.2)
+
MC5 10(90.9)
+++
9(81.8)
+++
0 0
MC6 0 0 0 0
MC7 0 11(100)
+++
7,2(65.2)
++
8,08(42.3)
+
Tetrasicline 11 11 11.04 19.12
Figures in parentheses are inhibition percentages compared to tetracyclin. Antibacterial activity is categorized as strong +++ for
inhibition ≥70%, moderate ++ for inhibition 50<70%, and weak + for inhibition 50% (Chan et al., 2007).
The extract of MC3 and MC5 endophytic fungal
isolates have antibacterial activity against E. coli
with 11 mm and 10 mm clear zone diameter, also
have antibacterial activity against S. aureus with
both 9 mm clear zone diameter (Table 1). This
means that the extract of secondary metabolites of
MC3 and MC5 isolates have a broad spectrum of
antibacterial activity, because it has antibacterial
activity against Gram-negative and Gram-positive
bacteria. This shows the differences in the content of
bioactive compounds found in endophytic fungi
isolates that act as antibacterial. Research conducted
by Ayepola and Adeniyi (2008), showed that
secondary metabolites from leaf extracts of
Eucalyptus camaldulensis including the plant family
Myrtaceae have a broad spectrum of antibacterial
activity in inhibiting bacterial growth, both Gram
positive and Gram negative bacteria.
3.2 Minimum Inhibitory Concentration
(MIC) of Secondary Metabolite
Extract of Endophytic Fungi
The MIC of secondary metabolite extract of
endophytic fungi of Melaleuca cajuputi leaves on
Eschrichia coli. MIC of MC
5
fungal isolates was
400 µg/mL with inhibition zone diameter 6,16 mm.
The MIC of secondary metabolite extract of MC
3
endophytic fungal isolates was 100 µg / mL with an
inhibition zone diameter 6.02 mm. Based on the
MIC value, it showed that MC
5
and MC
3
endophytic
fungi isolates had moderate antibacterial activity,
when compared with Batos et al. (2016) where the
Eugenia calycina plant extract has a MIC value of E.
coli was 500 µg / mL, where the range of values of
500 µg / mL - 1000 µg / mL means that it is slightly
active, a value of 100 µg / mL - 500 µg / mL being,
and KHM value less than 100 µg / mL means it is
very active.
The MIC of the secondary metabolite extract of
MC1 isolates on Staphylococcus aureus were 200
µg/mL with 6.1 mm inhibitory zone diameter of 6,1
mm. The MIC of MC
7
endophytic fungi isolate was
700 µg/mL with a inhibition zone diameter of 6.02
mm. The concentration 700 µg/mL means that it is
large enough to obtain a MIC value, compared with
the results of a study conducted by Banhos et al.
(2014) where extracts of the metabolites of the
endophytic fungi of the Myrcia guianensis plant
produced a MIC of S. aureus was 25 μg/mL. It is
suspected that the bioactive compounds in MC
7
fungal isolates are not strong enough to inhibit the
growth of S. aureus at low concentrations, besides it
is suspected that S. aureus bacteria have experienced
resistance to bioactive compounds contained in MC7
fungal isolates. According to Vuong et al. (2015), S.
aureus is one of the bacteria with a wide spread of
antibiotic resistance. This bacterium has been
resistant to penicillin, methicillin, even vancomycin,
one of the antibiotics that are still commonly used.
3.3 Thin Layer Chromatography
(TLC) Analysis
The results show that the color spot formed on the
TLC plates for the three extracts of Melaleuca
cajuputi endophytic fungal isolates which have
relatively strong antibacterial activity, the isolates
MC1, MC5, and MC7 were yellow. Based on the
results of research conducted by Fadel et al. (2018),
phenolic compounds when tested using thin layer
chromatography plates will be yellow, blue or pink.
Screening Endophytic Fungi of Melaleuca cajuputi Powell Leaves as Antibacterial Sources
199

The color spot formed for MC3 isolate extract
are yellow which shows phenol and brownish yellow
compounds, showing flavonoid compounds,
according to research conducted by Nugrahaningtyas
et al., (2005) that flavonoid compounds have a
brownish-yellow color to a red color. The color spot
formed on the plates of each different endophytic
fungi isolates showed the components of chemical
compounds contained in each different endophytic
fungi isolates.
This is consistent with the statement of Sharma
et al. (2016), different endophytic fungi in a plant
can produce different secondary metabolites. Based
on the result of Rf value it is known that there are
endophytic fungi isolates that have the same Rf
value also have the same color spots. This shows
that the possibility of chemical compounds
contained in the extract of secondary metabolites of
endophytic fungi isolates may be the same.
According to Ahamed et al. (2017), the Rf was a
general characteristic value that can change
depending on the polarity of the mobile phase and its
fixed phase. The Rf value indicates important
information regarding the polarity of the chemical
compounds to be identified. In addition, the Rf value
can also be used in determining good solvents as a
mobile phase in thin layer chromatography tests.
3.4 Characterization and Identification
of Endophytic Fungi of Melaleuca
cajuputi
The macroscopic and microscopic characteristics
endophytic fungi isolates of Melaleuca cajuputi leaf
are presented in Figure 1, 2 and Table 2.
Microscopic observations of MC1 endophytic fungi
isolates based on Figure 2 shows that hyphal fungi
isolates of MC1 endophytes are septate and hyaline-
colored, have short conidiophores and there are
conidia-forming cells in the cylindrical conidiophore
terminal, the conidia are rounded with smooth
surfaces.
Based on the microscopic characteristics
obtained it is suspected that MC1 endophytic fungi
isolates belong to the type of Scopulariopsis
candida. According to Gandjar et al. (1999), S.
candida has a colony diameter of 3-4 cm within 7
days. Reverse color beige to light brown. Its
conidiophores are short, have conidial-forming cells
that are cylindrical in shape, conidia in the form of
rounded to wide ovals, smooth-walled, and white to
beige.
The macroscopic and microscopic characteristics
endophytic fungi isolates of Melaleuca cajuputi leaf
are presented in Figure 3, 4 and Table 2. Based on
microscopic characters of MC3 endophytic fungi
isolates obtained that MC3 endophytic fungi isolates
was identified as Fusarium sporotrichiodes, with
characteristic hyphae and insular hyphae, there were
two-branched conidia, oval-shaped, three-sided
macroconidia, rounded microcondidia, and
hyaluronic hyphae. According to Samson et al.
(1995), F. sporotrichiodes has a white colony to
yellow and finally brown. Microconidia is
commonly found in aerial mycelia in the form of
ovoid, piriform or fusoid, 3-5 macroconidias.
Based on macroscopic and microscopic
characters of MC5 endophytic fungi isolates on
Figure 5, 6, and Table 6. Type of hyphae: septate;
hyphae color: hyaline; conidia color: hyaline;
clamydospore color: brownish. Based on
macroscopic and microscopic characters, MC5
endophytic fungi isolate was identified as Fusarium
equiseti. According to Samson et al., (1995),
Fusarium equiseti on PDA medium has a whitish
color and becomes creamy to brown in color, has a
lot of chlamydospores pale brown when old,
smooth-walled or rough, in chains or clumps, in
hyphae or conidia. The macroscopic and
microscopic characteristics endophytic fungi MC7
isolates of Melaleuca cajuputi leaves were presented
in Figure 7, 8 and Table 7.
Based on macroscopic and microscopic
characters of MC7 endophytic fungi isolates based
on Figure 7, 8 and Table 7 obtained results, MC7
endophytic fungi isolates had hyaline-colored
hyphae and insulated hyphae, there were rounded
and hyaline-colored columns, and had zigospores
with rough surfaces. Based on the characteristics
obtained, MC7 endophytic fungi isolate is suspected
to be a type of Mucor hiemalis. The microscopic
and macroscopic characteristics are in accordance
with Gandjar (1999), Mucor hiemalis has a rather
creamy yellow colony, a yellowish white reverse
color. The columns are round and hyaline, the
zigospores are semipurate or round in shape and the
surface is rough.
IMC-SciMath 2019 - The International MIPAnet Conference on Science and Mathematics (IMC-SciMath)
200
Figure 1: Colony images of MC1 endophytic fungal isolate of Melaleuca cajuputi on different medium. (a) PDA, (b) MEA,
(c) CDA, (d) CYA.
Table 2: Colony characteristics of MC1 endophytic fungal isolate of Melaleuca cajuputi on different medium.
Characteristics PDA medium MEA medium CDA medium CYA medium
Colony colo
r
White/ yellowish Cream Turbid white Turbid white
Colony reverse
colo
r
Turbid white/
yellowish
Cream Turbid white Turbid white
Medium color
around colony
Turbid white Turbid white Turbid white Turbid white
Colon
y
surface Smooth Smooth Smooth Smooth
Colony
diamete
r
4.75–5.7cm in 7 days 3.35–3.9cm in 7 days 3.05–3.25cm in 7 days 1.85–2.7cm in 7
da
y
s
Figure 2: Microscopical characteristics of MC1 isolate.
Figure 3: Colony images of MC3 endophytic fungal isolate of Melaleuca cajuputi on different medium. (a) PDA, (b) MEA,
(c) CDA, (d) CYA.
Table 3: Colony characteristics of MC3 endophytic fungal isolate of Melaleuca cajuputi on different medium.
Characteristics PDA medium MEA medium CDA medium CYA medium
Colony color White White White White
Colon
y
reverse colo
r
White Brownish white White White
Medium color around
colony
Turbid white Yellowish Turbid white Turbid white
Colon
y
surface Granular and notche
d
Powder
y
Floccose Floccose
Colony diameter 3.4-4.05 cm in 3 days 1.8-2.2cm in 7 days 3.4-4.05 cm in 3 days 2.35-5cm in 3 days
Screening Endophytic Fungi of Melaleuca cajuputi Powell Leaves as Antibacterial Sources
201
Figure 4: Microscopical characteristics of MC3 isolate.
Figure 5: Colony images of MC5 endophytic fungal isolate of Melaleuca cajuputi on different medium. (a) PDA, (b) MEA,
(c) CDA, (d) CYA.
Table 4: Colony characteristics of MC5 endophytic fungal isolate of Melaleuca cajuputi on different medium.
Characteristics PDA medium MEA medium CDA medium CYA medium
Colony color Greys white White Yellowish turbid white Cream
Colony reverse color Brownish white Brownish white Yellowish turbid white Cream
Medium color around colony Yellowish Yellowish Turbid white Turbid white
Colony surface Powdery Powdery Smooth Powdery
Colony diameter 1.8-2.5 cm in 7 days 2.95-3.75 cm in 7 days 3.15-3.95 cm in 7 days 1.75-2.35 cm in 7 days
Figure 6: Microscopical characteristics of MC5 isolate.
Figure 7: Colony images of MC7 endophytic fungal isolate of Melaleuca cajuputi on different medium. (a) PDA, (b) MEA,
(c) CDA, (d) CYA.
IMC-SciMath 2019 - The International MIPAnet Conference on Science and Mathematics (IMC-SciMath)
202

Table 5: Colony characteristics of MC7 endophytic fungal isolate of Melaleuca cajuputi on different medium.
Characteristics PDA medium MEA medium CDA medium CYA medium
Colony color Turbid white/yellowish Turbid white/yellowish Turbid white Turbid white
Colony reverse color White greyish brown Turbid white/yellowish Turbid white Turbid white
Medium color around colony Yellowish Turbid white Turbid white Turbid white
Colony surface Cottony Cottony Cottony Cottony
Colony diameter 4.65-5.25 cm in 3 days 4.85-5.55 cm in 3 days 5-5.75 cm in 3 days 5.5-6.05 cm in 3 days
Figure 8: Microscopical characteristics of MC7 isolate.
4 CONCLUSION
Endophytic fungi obtained from Melaleuca cajuputi
Powell obtained 7 isolates, 5 isolates obtained from
young leaves, and 2 isolates from old leaves. Ethyl
acetate extract of secondary metabolites endophytic
fungi of Melaleuca cajuputi Powell which classified
as strong and has a high percentage of antibacterial
activity, namely isolates of endophytic fungi MC1,
MC3, MC5, and MC7 against Escherichia coli and
Staphylococcus aureus. Minimum inhibitory
concentration (MIC) of secondary metabolite
extracts of MC5 and MC3 endophytic fungi isolates
against Escherichia coli were 400 µg / mL and 100
µg / mL respectively, while secondary metabolite
extracts of MC1 and MC7 endophytic fungi isolates
against Staphylococcus aureus bacteria were 200
mg / mL and 700 mg / mL. MC1 fungi isolates were
identified as Scopulariopsis candida, MC3 fungi
isolates were identified as Fusarium
sporotrichiodes, MC5 fungi isolates were identified
as Fusarium equiseti, , and MC7 fungi isolates were
identified as Mucor hiemalis.
REFERENCES
Ahamed, T., Rahman S.K.M., Shohael A.M. 2017. Thin
Layer Chromatographic Profiling and Phytochemical
Screening of Six Medicinal Plants in Bangladesh.
International Journal of Biosciences. 11(1) : 131 –
140.
Ajizah, A. 2004. Sensivitas Salmonella typhimmurium
terhadap Ekstrak Daun Psidium guajava L.
Bioscientiae. 1(1) : 31 – 38.
Al-Abd
1
, N.M., Zurainee Mohammed Nor, Marzida
Mansor, Fadzly Azhar, M.S. Hasan dan Mustafa
Kassim. 2015. Antioxidant, Antibacterial Activity, and
Phytochemical Characterization of Melaleuca cajuputi
extract. BMC Complementary and Alternative
Medicine. 15 : 385 – 397.
Al-Abd
2
, N.M., Zurainee M.N., Marzida M., MS Hasan
dan Mustafa K. 2016. Antifilarial and Antibiotic
Activities of Methanolic Extracts of Melaleuca
cajuputi flowers. Korean J Parasitol. 54(3) : 273 –
280.
Andries, J R., Paulina, N G., dan Aurelia, S. 2014. Uji
Aktivitas Antibakteri Ekstrak Bunga Cengkeh
terhadap Bakteri Streptococcus mutans secara In
Vitro. Jurnal e-Gigi. 2(2): 1-8.
Ayepola, O.O. dan Adeniyi B.A. 2008. The Antibacterial
Activity of Leaf Extracts of Eucalyptus camaldulensis
(Myrtaceae). Journal of Apllied Science Research.
4(11) : 1410 – 1413.
Banhos, E.F., Souza A.Q.L., Andrade J.C., Souza A.D.L.,
Koolen H.H.F., dan Albuquerque P.M. 2014.
Endophytic Fungi from Myrcia guianensis at The
Brazilian Amazon : Distribution and Bioactivity.
Brazilian Journal of Microbiology. 45(1) : 153 – 161.
Bastos, R.G., Rosa C.P., Oliver J.C., Silva N.C., Dias
A.L.T., Da Rocha C Q., Vilegas W., Da Silva G.A.,
dan Da Silva M.A. 2016. Chemical Characterization
and Antimicrobial Activity of Hydroethanolic Crude
Extract of Eugenia florida DC (Myrtaceae) Leaves.
International Jurnal of Pharmacy and Pharmaceutical
Sciences. 8(6) : 110 – 115.
Chan, E W C., Lim, Y Y., dan Mohammed, O. 2007.
Antioxidant and Antibacterial Activity of Leaves of
Screening Endophytic Fungi of Melaleuca cajuputi Powell Leaves as Antibacterial Sources
203

Etlingera Species (Zingiberaceae) in Peninsular
Malaysia. Food Chemistry. 104. 1586-1593.
Fadel, O., Rodrigues D.G., Girard L., Bauduin P., Castera
A.R., L’Hermitte A., Gaillard J.C., dan Diat O. 2018.
Seperation and Identification of Polar Polyphenols in
Oily Formulation Using High Performance Thin Layer
Chromatography and Mass Spectroscopy Techniques.
Oilseeds & Fats Corps and Lipids. 25(5) : 1 – 8.
Fatisa, Y.2013.Daya antibakteri ekstrak kulit dan biji buah
pulsa terhadap Staphylococcus aureus dan Escherichia
coli secara in vitro. Jurnal Peternakan (10) : 31-38.
Islam, M R., Shahnaj, P., Rikta, B., Nusrat, J., Nandita, D.,
dan Ekramul, I. 2013. Antibacterial and
Phytochemical Screening of Ethanol Extracts of
Manilkara zapota Leaves and Bark. International
Journal of Pharma Sciences. 3(6): 394-397.
Jamal, Y., Muhammad, I., Atit, K., dan Andria, A. 2008.
Diversitas dan Profil Metabolit Sekunder Jamur
Endofit yang Diisolasi dari Tumbuhan Gambir
(Uncaria gambler) Serta Aktivitas Biologisnya
Sebagai Antibakteri. Berita Biologi. 9 (1). 149-154.
Kumala, S. 2014. Mikroba Endofit: Pemanfaatan Mikroba
Endofit dalam Bidang Farmasi. Jakarta: PT. ISFI
Penerbitan. v + 105 hlm.
Nugrahaningtyas, K.D., Matsjeh S., dan Wahyuni T.D.
2005. Isolasi dan Identifikasi Senyawa Flavonoid
dalam Rimpang Temu Ireng (Curcuma aeruginosa
Roxb.). Biofarmasi. 3(1) : 32 – 38.
Radji, M. 2005. Peranan Bioteknologi dan Mikroba
Endofit dalam Pengembangan Obat Herbal. Majalah
Ilmu Kefarmasian 2 (3) :113-126.
Samson, R A., Ellen, S H., Jens, C F., dan Ole, F. 1995.
Introduction to Food-Borne Fungi Fourth Edition.
Netherlands: Centraalbureau voor Schimmelcultures. 1
+ 322 hlm.
Sharma, D., Pramanik A., Agrawal P.K. 2016. Evaluation
of Bioactive Secondary Metabolites from Endophytic
Fungus Pestalotiopsis neglecta BAB-5510 Isolated
from Leaves Cupressus torulosa D.Don. Biotech. 6(1)
: 1 – 14.
Shibuya, H., Agusta, A., Ohashi, K., Maehara, S., dan
Simanjuntak, P. 2005. Biooxidation of (+)-Catechin
and (-)-Epicatechin into 3,4-Dihydroxy Flavan
Derivatives by The Endophytic Fungus Diaporthe sp.
Isolated from A Tea Plant. Chem Pharm Bull. 53(7):
866-867.
Srikandace, Y., Yatri, H., dan Partomuan, S. 2007. Seleksi
Mikroba Endofit Curcuma zedoria dalam
Memproduksi Senyawa Kimia Antimikroba. Jurnal
Ilmu Kefarmasian Indonesia. 5 (2): 77-84
Stierle, A.,D.Stierle, G.Strobel, G.Bignami, and
P.Grothaus. 1995. Bioactive metabolites of the
endophytic fungi of pacific yew Taxus brevifolia.
Elsevier Scientific Publ.,Ireland.
Strobel, GA, and B.Daisy (2003). Bioprospecting for
microbial endophytes and their natural products.
Microbiol.and Mol. Biology Rev 67(4):491-502.
Tan, RX and WX.Zou.2001. Endophytes : a rich source of
functional metabolites. Nat Prod.Rep.18:448-459.
Widiana, A., Taufikurahman, Limin S.H., Hernaman I.
dan Manurung R. 2014. The Potential of Gelam
Leaves (Melaleuca cajuputi Powell) as Cattle Feed.
Pakistan Journal of Nutrition. 13(6) : 348 – 350.
Visagie, C M., Houbraken J., Jens, C F., Hong, S B.,
Klaassen, C H W., Perrone, G., Seifert, K A., Varga J.,
Yaguchi, T., dan Robert, A S. 2014. Identification and
Nomenclature of The Genus Penicillium. Studies In
Mycology. 78: 343-371.
Vuong, C., Yeh A.J., Cheng G.Y.C., dan Otto M. 2015.
Investigational Drugs to Treat Metichilin-resistant
Staphylococcus aureus. Expert Opinion
Investigational Drug. 25(1) : 73 – 93.
Zhao, J., Zhou, L., Wang, J., Shan, T., Zhong, L., Liu, X.,
dan Gao, X. 2010. Endophytic Fungi for Producing
Bioactive Compounds Originally from Their Host
Plants. Formatex. 567-576
IMC-SciMath 2019 - The International MIPAnet Conference on Science and Mathematics (IMC-SciMath)
204
